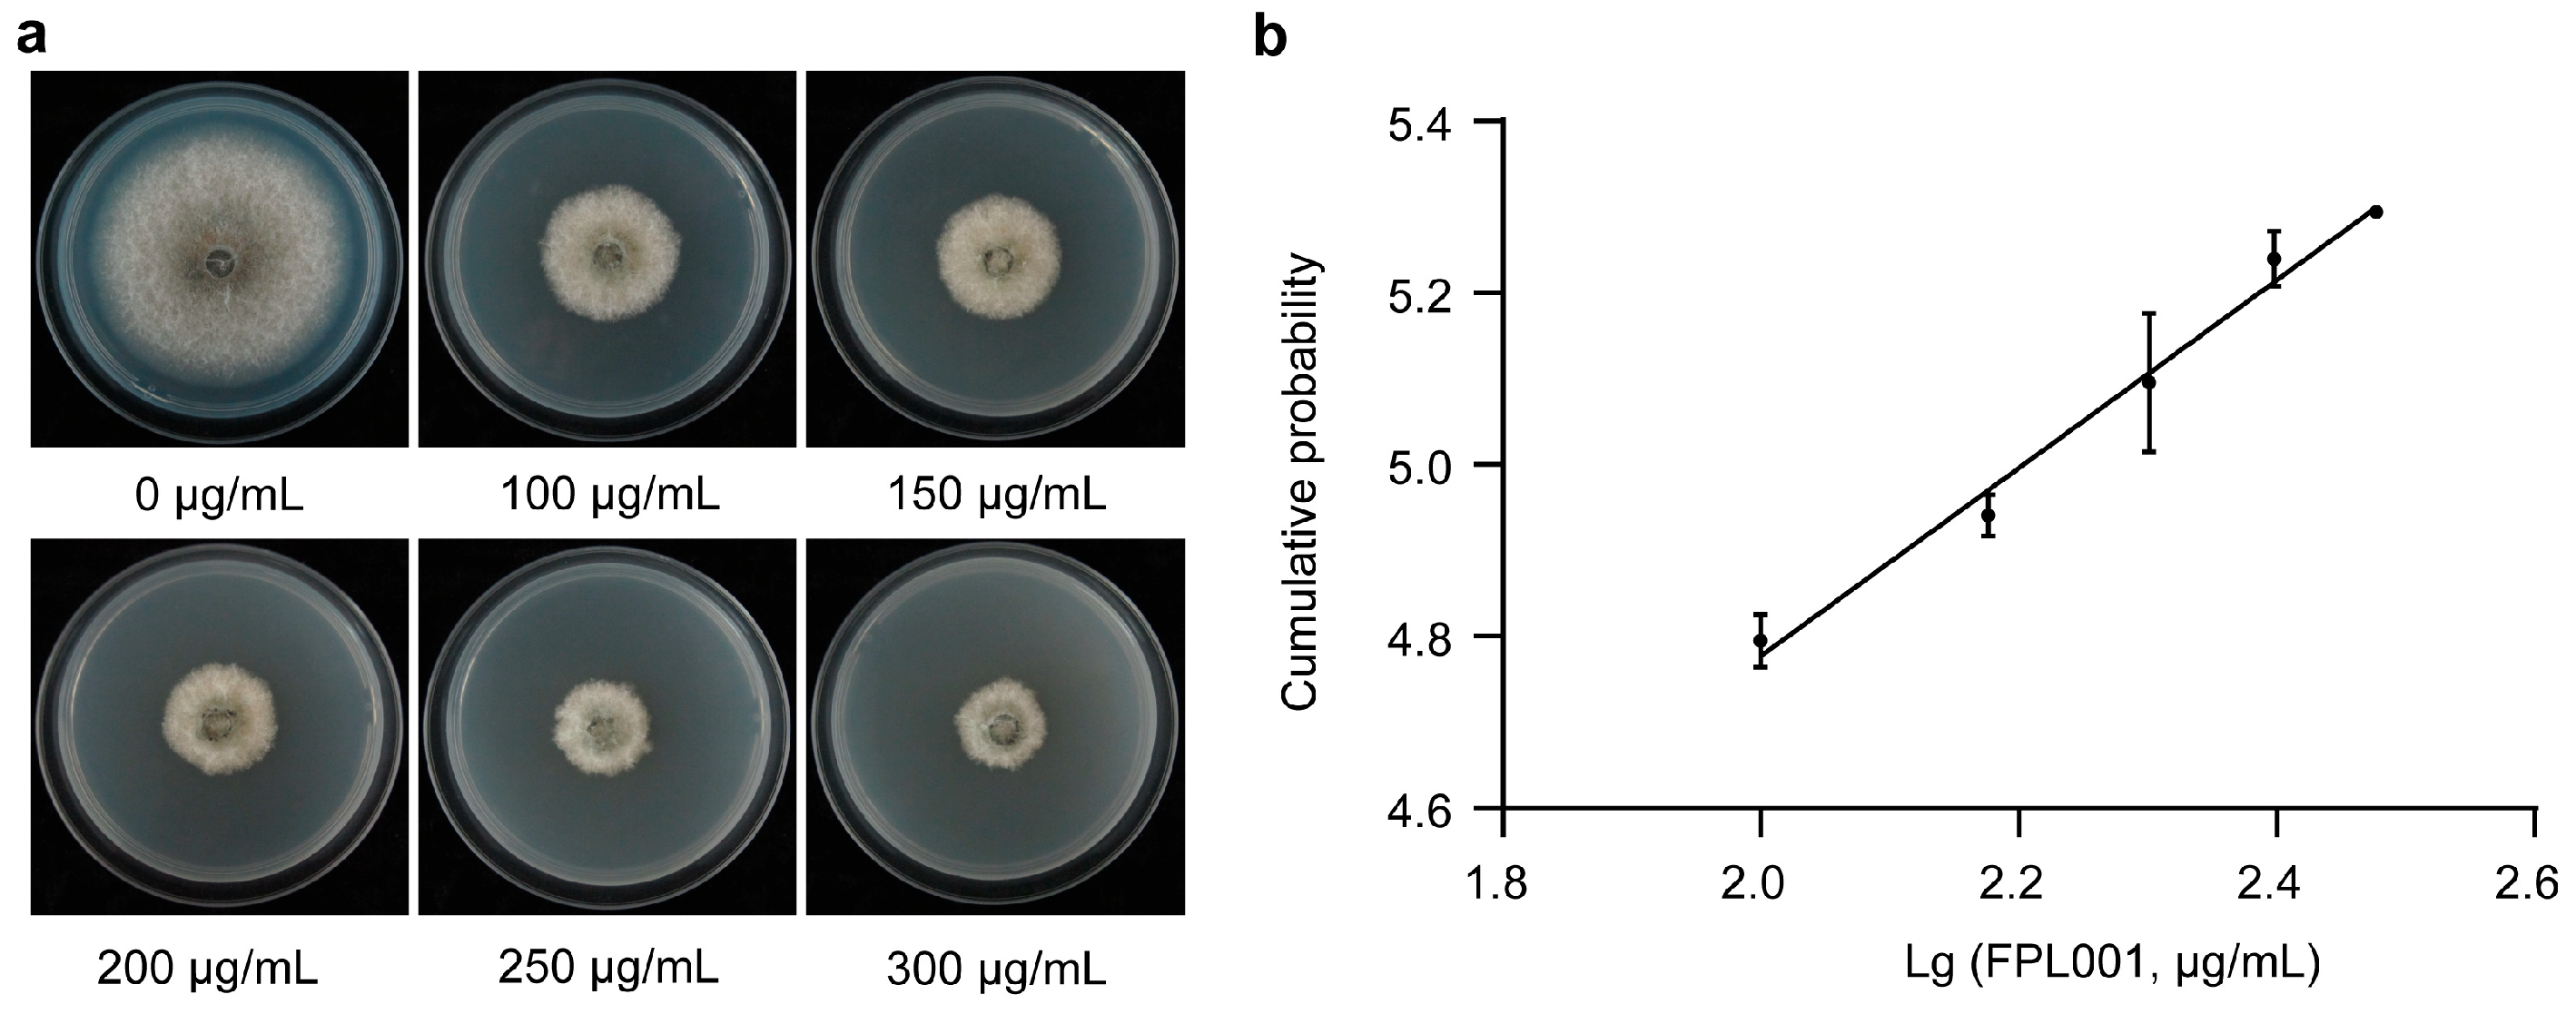
Forests 14 01172 g001

Evaluation of the Antifungal Activity of Polysubstituted Cyclic 1,2-Diketones against Colletotrichum gloeosporioides
Abstract
1. Introduction
2. Materials and Methods
2.1. Fungal Pathogen
2.2. Preparation of Compounds of Polysubstituted Cyclic 1,2-Diketones
2.3. Mycelial Growth Assays
2.4. Conidial Germination and Appressorium Formation Assays
2.5. Pathogenicity Tests In Vitro
2.6. Vegetative Growth Assays
2.7. Invasive Hyphae Assays
2.8. Safety Test of Compound FPL001 on Alfalfa and Silkworm
2.9. Statistical Analysis
3. Results
3.1. Suppression of the Mycelial Growth by Antifungal Compounds of Polysubstituted Cyclic 1,2-Diketones
3.2. Inhibitory Effects of FPL001 on Conidial Germination and Appressorium Formation of C. gloeosporioides
3.3. Compound FPL001 Reduced Pathogenicity of C. gloeosporioides
3.4. Effect of FPL001 on the Biomass of C. gloeosporioides
3.5. Effects of FPL001 on Invasive Hyphae of C. gloeosporioides
3.6. FPL001 Safe for Planting Alfalfa and Silkworm
4. Discussion
5. Conclusions
Supplementary Materials
Author Contributions
Funding
Data Availability Statement
Conflicts of Interest
References
- Ribas, A.D.R.E.; Spolti, P.; Del Ponte, E.M.; Donato, K.Z.; Schrekker, H.; Fuentefria, A.M. Is the Emergence of Fungal Resistance to Medical Triazoles Related to their Use in the Agroecosystems? A Mini Review. Braz. J. Microbiol. 2016, 47, 793–799. [Google Scholar] [CrossRef] [PubMed]
- Russell, P.E. A Century of Fungicide Evolution. J. Agric. Sci. 2005, 143, 11–25. [Google Scholar] [CrossRef]
- Noel, Z.A.; Longley, R.; Benucci, G.M.N.; Trail, F.; Chilvers, M.I.; Bonito, G. Non-Target Impacts of Fungicide Disturbance on Phyllosphere Yeasts in Conventional and No-Till Management. ISME Commun. 2022, 2, 19. [Google Scholar] [CrossRef] [PubMed]
- Lulla, A.; Barnhill, L.; Bitan, G.; Ivanova, M.I.; Nguyen, B.; O’Donnell, K.; Stahl, M.C.; Yamashiro, C.; Klarner, F.G.; Schrader, T.; et al. Neurotoxicity of the Parkinson Disease-Associated Pesticide Ziram is Synuclein-Dependent in Zebrafish Embryos. Environ. Health Perspect. 2016, 124, 1766–1775. [Google Scholar] [CrossRef] [PubMed]
- Ioriatti, C.; Pasqualini, E.; Toniolli, A. Effects of the Fungicides Mancozed and Dithianon on Mortality and Reproduction of the Predatory Mite Amblyseius andersoni. Exp. Appl. Acarol. 1992, 15, 109–116. [Google Scholar] [CrossRef]
- Cao, F.J.; Zhu, L.Z.; Li, H.; Yu, S.; Wang, C.J.; Qiu, L.H. Reproductive Toxicity of Azoxystrobin to Adult Zebrafish (Danio rerio). Environ. Pollut. 2016, 219, 1109–1121. [Google Scholar] [CrossRef]
- Malhotra, N.; Ger, T.R.; Uapipatanakul, B.; Huang, J.C.; Chen, K.; Hsiao, C.D. Review of Copper and Copper Nanoparticle Toxicity in Fish. Nanomaterials 2020, 10, 1126. [Google Scholar] [CrossRef]
- Liu, X.M.; Cao, A.C.; Yan, D.D.; Ouyang, C.B.; Wang, Q.X.; Li, Y. Overview of Mechanisms and Uses of Biopesticides. Int. J. Pest Manag. 2021, 67, 65–72. [Google Scholar] [CrossRef]
- Subba, R.; Mathur, P. Functional Attributes of Microbial and Plant Based Biofungicides for the Defense Priming of Crop Plants. Theor. Exp. Plant Physiol. 2022, 34, 301–333. [Google Scholar] [CrossRef]
- Yoon, M.Y.; Cha, B.; Kim, J.C. Recent Trends in Studies on Botanical Fungicides in Agriculture. Plant Pathol. J. 2013, 29, 1–9. [Google Scholar] [CrossRef]
- Filipic, V.J.; Underwood, J.C.; Willits, C.O. The Identification of Methylcyclopentenolone and Other Compounds in Maple Sirup Flavor Extract. J. Food Sci. 1965, 30, 1008–1015. [Google Scholar] [CrossRef]
- Arnarp, J.; Enzell, C.R.; Petersson, K.; Pettersson, T. Tobacco Smoke Chemistry. 1. A Chemical and Mass Spectrometric Study of Tobacco Smoke Alkyl 2-Hydroxy-2-Cyclopentenones. Acta Chem. Scand. 1986, 40, 839–854. [Google Scholar] [CrossRef] [PubMed]
- Pereira, J.; Pereira, J.; Camara, J.S. Effectiveness of Different Solid-Phase Microextraction Fibres for Differentiation of Selected Madeira Island Fruits Based on their Volatile Metabolite Profile-Identification of Novel Compounds. Talanta 2011, 83, 899–906. [Google Scholar] [CrossRef] [PubMed]
- Chung, J.H.; Choi, S.Y.; Kim, J.Y.; Kim, D.H.; Lee, J.W.; Choi, J.S.; Chung, H.Y. 3-Methyl-1,2-cyclopentanedione Down-Regulates Age-Related NF-kB Signaling Cascade. J. Agric. Food Chem. 2007, 55, 6787–6792. [Google Scholar] [CrossRef]
- Sandoval-Montemayor, N.E.; Garcia, A.; Elizondo-Trevino, E.; Garza-Gonzalez, E.; Alvarez, L.; Camacho-Corona, M.D. Chemical Composition of Hexane Extract of Citrus Aurantifolia and Anti-Mycobacterium tuberculosis Activity of Some of its Constituents. Molecules 2012, 17, 11173–11184. [Google Scholar] [CrossRef]
- Marko, D.; Habermeyer, M.; Kemeny, M.; Weyand, U.; Niederberger, E.; Frank, O.; Hofmann, T. Maillard Reaction Products Modulating the Growth of Human Tumor Cells in Vitro. Chem. Res. Toxicol. 2003, 16, 48–55. [Google Scholar] [CrossRef]
- Liu, X.; Cui, R.; Shi, J.; Jiang, Q.; Gao, J.; Wang, Z.; Li, X. Separation and Microencapsulation of Antibacterial Compounds from Wood Vinegar. Process. Biochem. 2021, 110, 275–281. [Google Scholar] [CrossRef]
- Wang, Z.Q.; Reinus, B.J.; Dong, G.B. Catalytic Intermolecular C-alkylation of 1,2-Diketones with Simple Olefins: A Recyclable Directing Group Strategy. J. Am. Chem. Soc. 2012, 134, 13954–13957. [Google Scholar] [CrossRef]
- Trost, B.M.; Dong, G.B.; Vance, J.A. Cyclic 1,2-Diketones as Core Building Blocks: A Strategy for the Total Synthesis of (-)-Terpestacin. Chem. Eur. J. 2010, 16, 6265–6277. [Google Scholar] [CrossRef]
- Boudriga, S.; Haddad, S.; Murugaiyah, V.; Askri, M.; Knorr, M.; Strohmann, C.; Golz, C. Three-Component Access to Functionalized Spiropyrrolidine Heterocyclic Scaffolds and their Cholinesterase Inhibitory Activity. Molecules 2020, 25, 1963. [Google Scholar] [CrossRef]
- Kang, S.; Lee, S.; Jeon, M.; Kim, S.M.; Kim, Y.S.; Han, H.; Yang, J.W. In Situ Generation of Hydroperoxide by Oxidation of Benzhydrols to Benzophenones Using Sodium Hydride under Oxygen Atmosphere: Use for the Oxidative Cleavage of Cyclic 1,2-Diketones to Dicarboxylic Acids. Tetrahedron Lett. 2013, 54, 373–376. [Google Scholar] [CrossRef]
- Chen, H.; Bai, J.; Fang, Z.F.; Yu, S.S.; Ma, S.G.; Xu, S.; Li, Y.; Qu, J.; Ren, J.H.; Li, L.; et al. Indole Alkaloids and Quassinoids from the Stems of Brucea Mollis. J. Nat. Prod. 2011, 74, 2438–2445. [Google Scholar] [CrossRef] [PubMed]
- Dean, R.; Van Kan, J.; Pretorius, Z.A.; Hammond-Kosack, K.E.; Di Pietro, A.; Spanu, P.D.; Rudd, J.J.; Dickman, M.; Kahmann, R.; Ellis, J.; et al. The Top 10 Fungal Pathogens in Molecular Plant Pathology. Mol. Plant Pathol. 2012, 13, 414–430. [Google Scholar] [CrossRef]
- Diao, Y.Z.; Zhang, C.; Liu, F.; Wang, W.Z.; Liu, L.; Cai, L.; Liu, X.L. Colletotrichum Species causing Anthracnose Disease of Chili in China. Persoonia 2017, 38, 20–37. [Google Scholar] [CrossRef]
- Fu, M.; Crous, P.W.; Bai, Q.; Zhang, P.F.; Xiang, J.; Guo, Y.S.; Zhao, F.F.; Yang, M.M.; Hong, N.; Xu, W.X.; et al. Colletotrichum Species Associated with Anthracnose of Pyrus spp. in China. Persoonia 2019, 42, 1–35. [Google Scholar] [CrossRef]
- Liu, F.; Weir, B.S.; Damm, U.; Crous, P.W.; Wang, Y.; Liu, B.; Wang, M.; Zhang, M.; Cai, L. Unravelling Colletotrichum Species Associated with Camellia: Employing ApMat and GS Loci to Resolve Species in the C. gloeosporioides Complex. Persoonia 2015, 35, 63–86. [Google Scholar] [CrossRef] [PubMed]
- Wang, W.X.; de Silva, D.D.; Moslemi, A.; Edwards, J.; Ades, P.K.; Crous, P.W.; Taylor, P. Colletotrichum Species Causing Anthracnose of Citrus in Australia. J. Fungi 2021, 7, 47. [Google Scholar] [CrossRef]
- Palaniyandi, S.A.; Yang, S.H.; Cheng, J.H.; Meng, L.; Suh, J.W. Biological Control of Anthracnose (Colletotrichum gloeosporioides) in Yam by Streptomyces Sp.Mjm5763. J. Appl. Microbiol. 2011, 111, 443–455. [Google Scholar] [CrossRef]
- He, J.; Li, D.W.; Zhu, Y.N.; Si, Y.Z.; Huang, J.H.; Zhu, L.H.; Ye, J.R.; Huang, L. Diversity and Pathogenicity of Colletotrichum Species causing Anthracnose on Cunninghamia lanceolata. Plant Pathol. 2022, 71, 1757–1773. [Google Scholar] [CrossRef]
- Meng, X.T.; Chen, D.F.; Cao, X.J.; Luo, J.Y.; Wang, F.; Huang, S.L. Synthesis of Polysubstituted Cyclic 1,2-Diketones Enabled by Iterative Sulfoxide-Mediated Arylation. Chem. Commun. 2019, 55, 12495–12498. [Google Scholar] [CrossRef]
- Zhao, J.; Wang, Y.; Liu, Q.; Lu, X.; Tian, Z.; Long, C. Investigation of Specific Molecular Marker and EC50 Values of Guazatine for Geotrichum citriaurantii on Citrus in China. Sci. Hortic. 2023, 310, 111772. [Google Scholar] [CrossRef]
- Pan, Y.T.; Li, L.W.; Yang, J.Y.; Li, B.; Zhang, Y.Z.; Wang, P.; Huang, L. Involvement of Protein Kinase CgSat4 in Potassium Uptake, Cation Tolerance, and Full Virulence in Colletotrichum gloeosporioides. Front. Plant Sci. 2022, 13, 773898. [Google Scholar] [CrossRef] [PubMed]
- Bian, J.Y.; Fang, Y.L.; Song, Q.; Sun, M.L.; Yang, J.Y.; Ju, Y.W.; Li, D.W.; Huang, L. The Fungal Endophyte Epicoccum dendrobii as a Potential Biocontrol Agent against Colletotrichum gloeosporioides. Phytopathology 2021, 111, 293–303. [Google Scholar] [CrossRef] [PubMed]
- Wang, P.; Li, B.; Pan, Y.T.; Zhang, Y.Z.; Li, D.W.; Huang, L. Calcineurin-Responsive Transcription Factor CgCrza is Required for Cell Wall Integrity and Infection-Related Morphogenesis in Colletotrichum gloeosporioides. Plant Pathol. J. 2020, 36, 385–397. [Google Scholar] [CrossRef]
- Yahaghi, Z.; Shirvani, M.; Nourbakhsh, F.; Pueyo, J.J. Uptake and Effects of Lead and Zinc on Alfalfa (Medicago sativa L.) Seed Germination and Seedling Growth: Role of Plant Growth Promoting Bacteria. S. Afr. J. Bot. 2019, 124, 573–582. [Google Scholar] [CrossRef]
- Yu, R.X.; Wang, Y.H.; Hu, X.Q.; Wu, S.G.; Cai, L.M.; Zhao, X.P. Individual and Joint Acute Toxicities of Selected Insecticides against Bombyx mori (Lepidoptera: Bombycidae). J. Econ. Entomol. 2016, 109, 327–333. [Google Scholar] [CrossRef]
- Qi, Z.; Liu, M.; Dong, Y.; Zhu, Q.; Li, L.; Li, B.; Yang, J.; Li, Y.; Ru, Y.; Zhang, H.; et al. The Syntaxin Protein (MoSyn8) Mediates Intracellular Trafficking to Regulate Conidiogenesis and Pathogenicity of Rice Blast Fungus. New Phytol. 2016, 209, 1655–1667. [Google Scholar] [CrossRef]
- Banerjee, S.; Nau, S.; Hochwald, S.N.; Xie, H.; Zhang, J. Anticancer Properties and Mechanisms of Botanical Derivatives. Phytomed. Plus 2023, 3, 100396. [Google Scholar] [CrossRef]
- Yang, C.; Hamel, C.; Vujanovic, V.; Gan, Y. Fungicide: Modes of Action and Possible Impact on Nontarget Microorganisms. Int. Sch. Res. Not. 2011, 2011, 130289. [Google Scholar] [CrossRef]
- Mi, Y.Q.; Tan, W.Q.; Zhang, J.J.; Wei, L.J.; Chen, Y.; Li, Q.; Dong, F.; Guo, Z.Y. Synthesis, Characterization, and Antifungal Property of Hydroxypropyltrimethyl Ammonium Chitosan Halogenated Acetates. Mar. Drugs 2018, 16, 315. [Google Scholar] [CrossRef]
- Sernaite, L.; Rasiukeviciute, N.; Valiuskaite, A. The Extracts of Cinnamon and Clove as Potential Biofungicides against Strawberry Grey Mould. Plants 2020, 9, 613. [Google Scholar] [CrossRef] [PubMed]
- He, J.G.; Dou, M.L.; Xie, J.; Hou, S.; Liu, Q.F.; Hu, Z.; Zhang, B.J.; Zheng, S.; Yin, F.M.; Zhang, M.; et al. Discovery of Zeylenone from Uvaria grandiflora as a Potential Botanical Fungicide. Pest Manag. Sci. 2021, 77, 5407–5417. [Google Scholar] [CrossRef] [PubMed]
- Wang, W.J.; Wan, X.; Liu, J.J.; Wang, J.P.; Zhu, H.C.; Chen, C.M.; Zhang, Y.H. Two New Terpenoids from Talaromyces Purpurogenus. Mar. Drugs 2018, 16, 150. [Google Scholar] [CrossRef] [PubMed]
- Bhowmick, S.; Beckmann, M.; Shen, J.Y.; Mur, L. Identification and Metabolomic Characterization of Potent Anti-Mrsa Phloroglucinol Derivatives from Dryopteris Crassirhizoma Nakai (Polypodiaceae). Front. Pharmacol. 2022, 13, 961087. [Google Scholar] [CrossRef]
- Arif, T.; Bhosale, J.D.; Kumar, N.; Mandal, T.K.; Bendre, R.S.; Lavekar, G.S.; Dabur, R. Natural Products--Antifungal Agents Derived from Plants. J. Asian Nat. Prod. Res. 2009, 11, 621–638. [Google Scholar] [CrossRef]
- Nevagi, R.J.; Dighe, S.N.; Dighe, S.N. Biological and Medicinal Significance of Benzofuran. Eur. J. Med. Chem. 2015, 97, 561–581. [Google Scholar] [CrossRef]
- Tundis, R.; Loizzo, M.R.; Menichini, F. An Overview on Chemical Aspects and Potential Health Benefits of Limonoids and their Derivatives. Crit. Rev. Food Sci. Nutr. 2014, 54, 225–250. [Google Scholar] [CrossRef]
- Wang, C.M.; Guan, W.; Fang, S.; Chen, H.; Li, Y.Q.; Cai, C.; Fan, Y.J.; Shi, Z.Q. Antifungal Activity of the Osthol Derivative Js-B against Phytophthora capsici. J. Asian Nat. Prod. Res. 2010, 12, 672–679. [Google Scholar] [CrossRef]
- Cheng, X.A.; He, H.Q.; Dong, F.Y.; Xu, C.C.; Zhang, H.H.; Liu, Z.M.; Lv, X.J.; Wu, Y.H.; Jiang, X.H.; Qin, X.J. Synthesis of Halopyrazole Matrine Derivatives and their Insecticidal and Fungicidal Activities. Molecules 2022, 27, 4974. [Google Scholar] [CrossRef]

| Treatment | Colony Diameter (cm) | Inhibition Rate (%) |
|---|---|---|
| FPL001 | 2.16 ± 0.06 a | 58.85 ± 1.30 a |
| FPL002 | 2.29 ± 0.07 ab | 56.44 ± 1.25 b |
| FPL003 | 2.40 ± 0.05 b | 54.43 ± 1.73 b |
| FPL004 | 2.81 ± 0.13 c | 46.62 ± 1.61 c |
| FPL005 | 3.23 ± 0.15 d | 38.51 ± 2.15 d |
| Control | 5.26 ± 0.29 e | 0 |
Disclaimer/Publisher’s Note: The statements, opinions and data contained in all publications are solely those of the individual author(s) and contributor(s) and not of MDPI and/or the editor(s). MDPI and/or the editor(s) disclaim responsibility for any injury to people or property resulting from any ideas, methods, instructions or products referred to in the content. |
© 2023 by the authors. Licensee MDPI, Basel, Switzerland. This article is an open access article distributed under the terms and conditions of the Creative Commons Attribution (CC BY) license (https://creativecommons.org/licenses/by/4.0/).
Share and Cite
Wang, Q.; Meng, X.; Sun, M.; Wang, Z.; He, J.; Huang, S.; Huang, L. Evaluation of the Antifungal Activity of Polysubstituted Cyclic 1,2-Diketones against Colletotrichum gloeosporioides. Forests 2023, 14, 1172. https://doi.org/10.3390/f14061172
Wang Q, Meng X, Sun M, Wang Z, He J, Huang S, Huang L. Evaluation of the Antifungal Activity of Polysubstituted Cyclic 1,2-Diketones against Colletotrichum gloeosporioides. Forests. 2023; 14(6):1172. https://doi.org/10.3390/f14061172
Chicago/Turabian StyleWang, Qiuyue, Xiangtai Meng, Meiling Sun, Zhi Wang, Jiao He, Shenlin Huang, and Lin Huang. 2023. "Evaluation of the Antifungal Activity of Polysubstituted Cyclic 1,2-Diketones against Colletotrichum gloeosporioides" Forests 14, no. 6: 1172. https://doi.org/10.3390/f14061172
APA StyleWang, Q., Meng, X., Sun, M., Wang, Z., He, J., Huang, S., & Huang, L. (2023). Evaluation of the Antifungal Activity of Polysubstituted Cyclic 1,2-Diketones against Colletotrichum gloeosporioides. Forests, 14(6), 1172. https://doi.org/10.3390/f14061172

